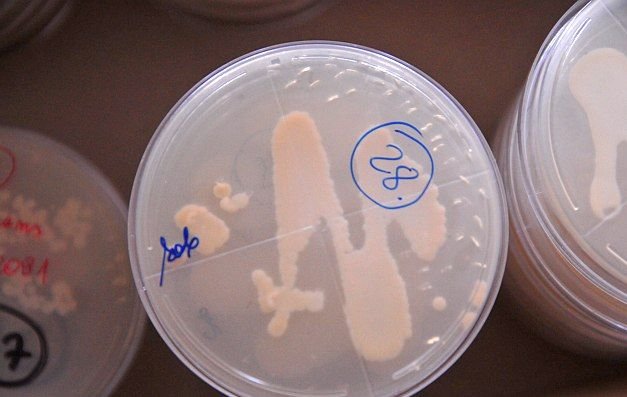

Szczerze nie rozumiem, dlaczego tak wielu dziennikarzy - od lewa do prawa - tak bardzo chce poznać poglądy pana T. Terlikowskiego, niemal na każdy temat. Po raz kolejny, po przeczytaniu materiału na temat szczepionki HPV, w którym to właśnie ten publicysta wcielił się w rolę eksperta – opadły mi ręce. Dodam, że był to artykuł w Newsweeku.
REKLAMA
Uważam, że takie wypowiedzi nie powinny być publikowane. Po co ludzi drażnić, a nawet obrażać. A może o to chodzi, by rozwścieczyć internautów, by zestawiając ze sobą skrajne opinie – pozyskiwać czytelników? Wolałbym przeczytać opinię eksperta, zamiast wywodów nie mających potwierdzenia w publikacjach naukowych. Publicysta katolicki nie ma patentu na pisanie o wszystkim i wypowiadania się na każdy możliwy temat.
Jakiś czas temu na Facebooku przeczytałem u pana Terlikowskiego wpis sugerujący, że rak szyjki macicy jest rakiem zdrady. Napisałem kilka zdań oburzony tym stwierdzeniem – ale odpowiedzi się nie doczekałem.
W artykule w Newsweeku opublikowanym 14.08.2015 r. przeczytałem: „Tomasz i Małgorzata Terlikowscy przekonują, że dziewczynki szczepione przeciwko wirusowi HPV, który powoduje raka szyjki macicy, będą bardziej swawolne seksualnie”.
Jeżeli ktoś wychowuje dzieci do wierności małżeńskiej – to szczepionka na HPV ma spowodować nagłe odrzucenie tych nauk i prowadzić do rozwiązłości? Szczerze nie rozumiem pana Tomasza i jego małżonki.
Całe oburzenie szanownych państwa wynika faktu, że Ministerstwo Zdrowia chce wprowadzić program darmowych szczepień dla dziewczynek przeciwko wirusowi brodawczaka ludzkiego (HPV), który jest przyczyną raka szyjki macicy (RSM).
Wstępne badania potwierdzają dość wysoką skuteczność szczepionek obecnych na rynku. Jednak nie brakuje sceptyków, którzy uważają, że darmowe szczepienia nie są najlepszym rozwiązaniem. Przywołują tu przypadek Rumunii, w której z darmowych szczepień skorzystał niski procent dziewcząt. Jeszcze inni widzą wyłącznie korzyści dla firm farmaceutycznych. Ale tu chodzi przede wszystkim o ludzkie życie.
„W jaki sposób według Terlikowskich, można chronić się przed rakiem szyjki macicy? To proste - zamiast wykupować szczepionkę, przeznaczyć te pieniądze na kampanię promującą czystość i wierność małżeńską. Zdaniem Terlikowskiego będzie to długofalowa inwestycja, ale jej efektem będzie realny rozwój moralny społeczeństwa” – czytam w Newsweeku.
Niestety, wbrew opiniom pana Terlikowskiego, sama wierność małżeńska nie wystarcza by uniknąć raka szyjki macicy. Jestem oburzony używaniem tego typu argumentów, bo obrażają one kobiety, które mając jednego partnera seksualnego – doświadczyły niestety RSM.
Rak szyjki macicy jest najczęściej występującą chorobą nowotworową w populacji kobiet. Każdego roku w samej Europie odnotowuje się 60 tys. zachorowań na różne rodzaje RSM.
Szczepionki obecne na rynku zapewniają ochronę przed HPV 16, 18 i 6 – które są odpowiedzialne za ogromną większość przypadków raka szyjki macicy. Szczepionka dwuwalentna GSK Cervarix ma chronić przed HPV 16 i 18, natomiast szczepionka czterowalentna MSD Silgard/Gardasil przed HPV 16, 18, 11 i 6. Według WHO istotne efekty szczepień populacyjnych będą widoczne po upływie 30 lat.
Istnieją jeszcze inne rodzaje HPV, dlatego z całą pewnością szczepionka nie jest w stanie wyeliminować w 100% wystąpienia tego typu nowotworu, choć może niezwykle skutecznie obniżyć jego występowanie. Dlatego obok zastosowania szczepionki kobiety powinny odbywać regularne badania cytologiczne. W Polsce poddaje się im niestety ciągle zbyt mały procent.
Program darmowych szczepień dla dziewcząt przeciwko wirusowi brodawczaka ludzkiego to wielkie osiągnięcie. Oczywiście należałoby program ministerstwa poprzeć teraz kampanią edukacyjną.
Nie sądzę, aby ministerstwo zmuszało rodziców do tego, by szczepili swoje dzieci pod groźbą kary. Jednak warto, tak myślę, być odpowiedzialnym rodzicem i już teraz szukać informacji na temat nie tylko wirusa HPV, ale także raka szyjki macicy. Przyszła decyzja o zaszczepieniu córki bądź nie – będzie miała określone konsekwencje.
I nie chodzi tu o porównywanie kosztów szczepionek z leczeniem onkologicznym pacjentek z RSC. Tu chodzi o ludzkie życie i zdrowie, o ludzkie szczęście. W zasadzie o odrobinę wyobraźni.
Z danych publikowanych przez specjalistów wynika, że nie wszystkie zakażenia wirusem HPV przekształcają się w zmiany nowotworowe. Największe ryzyko zakażenia ma miejsce tuż po rozpoczęciu inicjacji seksualnej. Choć HPV jest przenoszony drogą płciową, to sam stosunek penetracyjny do zakażenia nie jest konieczny – wystarczy niekiedy kontakt skórny. Wzorzec zakażeń różni się w zależności od regionu i statusu ekonomiczno-społecznego.
Zespół Ekspertów PTG potwierdza, że badania epidemiologiczne doprowadziły do zidentyfikowania niektórych czynników, które sprzyjają wystąpieniu infekcji HPV oraz zwiększają ryzyko infekcji przetrwałej. Są to: palenie papierosów, wysoka rodność, długotrwałe stosowanie doustnej antykoncepcji oraz współistnienie innych infekcji przenoszonych drogą płciową.
Przeprowadzone badania wśród lekarzy pediatrów, ginekologów i położników oraz lekarzy rodzinnych wykazały, że 76% ginekologów ocenia swą wiedzę jako wystarczającą w zakresie rozumienia zagadnień związanych z zakażeniami HPV, ale tylko 26% lekarzy rodzinnych i 14% pediatrów.
Ciekawe jak wiedza na ten temat prezentuje się u dziennikarzy i publicystów, także tych określanych mianem katolickich.
